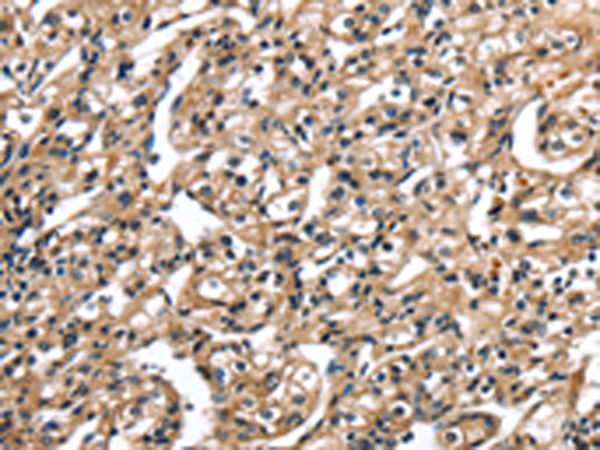

-
分类: 科研抗体货号: P08849别名: DP2应用: IHC反应种属: Human, Mouse
-
分类: 科研抗体货号: P08850别名: TCFEB; BHLHE35; ALPHATFEB应用: IHC反应种属: Human, Mouse
-
分类: 科研抗体货号: P08871别名: RNF18; TRIM49A; TRIM49L2应用: WB,IHC反应种属: Human
-
分类: 科研抗体货号: P08848别名: Rhes; TEM2; MGC:4834应用: WB,IHC反应种属: Human, Mouse
-
分类: 科研抗体货号: P08870别名:应用: WB,IHC反应种属: Human, Mouse
-
分类: 科研抗体货号: P08847别名: HRF; p02; p23; TCTP应用: WB,IHC反应种属: Human, Mouse, Rat
-
分类: 科研抗体货号: P08868别名: EBBP应用: IHC反应种属: Human, Mouse
-
分类: 科研抗体货号: P08846别名: E2A; E47; p75; AGM8; ITF1; VDIR; TCF-3; bHLHb21应用: IHC反应种属: Human
-
分类: 科研抗体货号: P08866别名: RFP; RNF76应用: WB,IHC反应种属: Human, Mouse
-
分类: 科研抗体货号: P08844别名: TBX7; TBX13应用: IHC反应种属: Human

鄂公网安备42018502007531号
鄂公网安备42018502007531号

